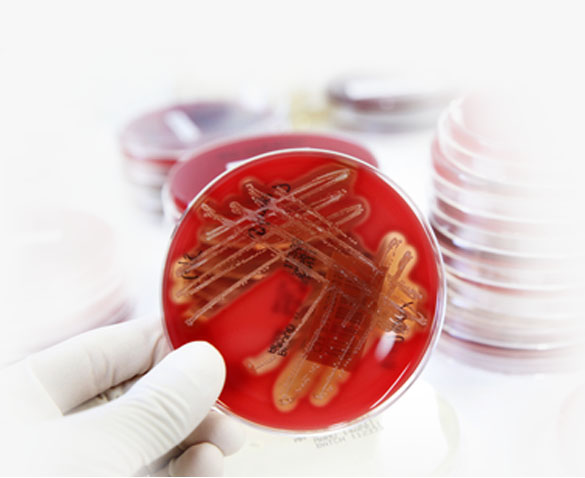

BADANIE W KIERUNKU WIRUSA HPV ORAZ CYTOLOGIA LBC
Zakażenie wirusem HPV może przebiegać w sposób bezobjawowy lub jawny klinicznie. Obecność wirusa jest ściśle powiązana z podwyższonym ryzykiem zachorowania na raka szyjki macicy. WYKONUJEMY TAKŻE GINEKOLOGICZNĄ PŁYNNĄ CYTOLOGIE CIENKOWARSTWOWĄ LBC (ang. Liquid Based Cytology) opiera się ona na unowocześnionej technice przygotowania preparatu cytologicznego i jest obecnie także niezbędnym narzędziem w profilaktyce stanów zapalnych jak i nowotworowych. Obydwa badania polegają na pobrania wymazu ginekologicznego. W celu umówienia się na wizytę wymagana jest wcześniejsza rejestracja 662 593 947.